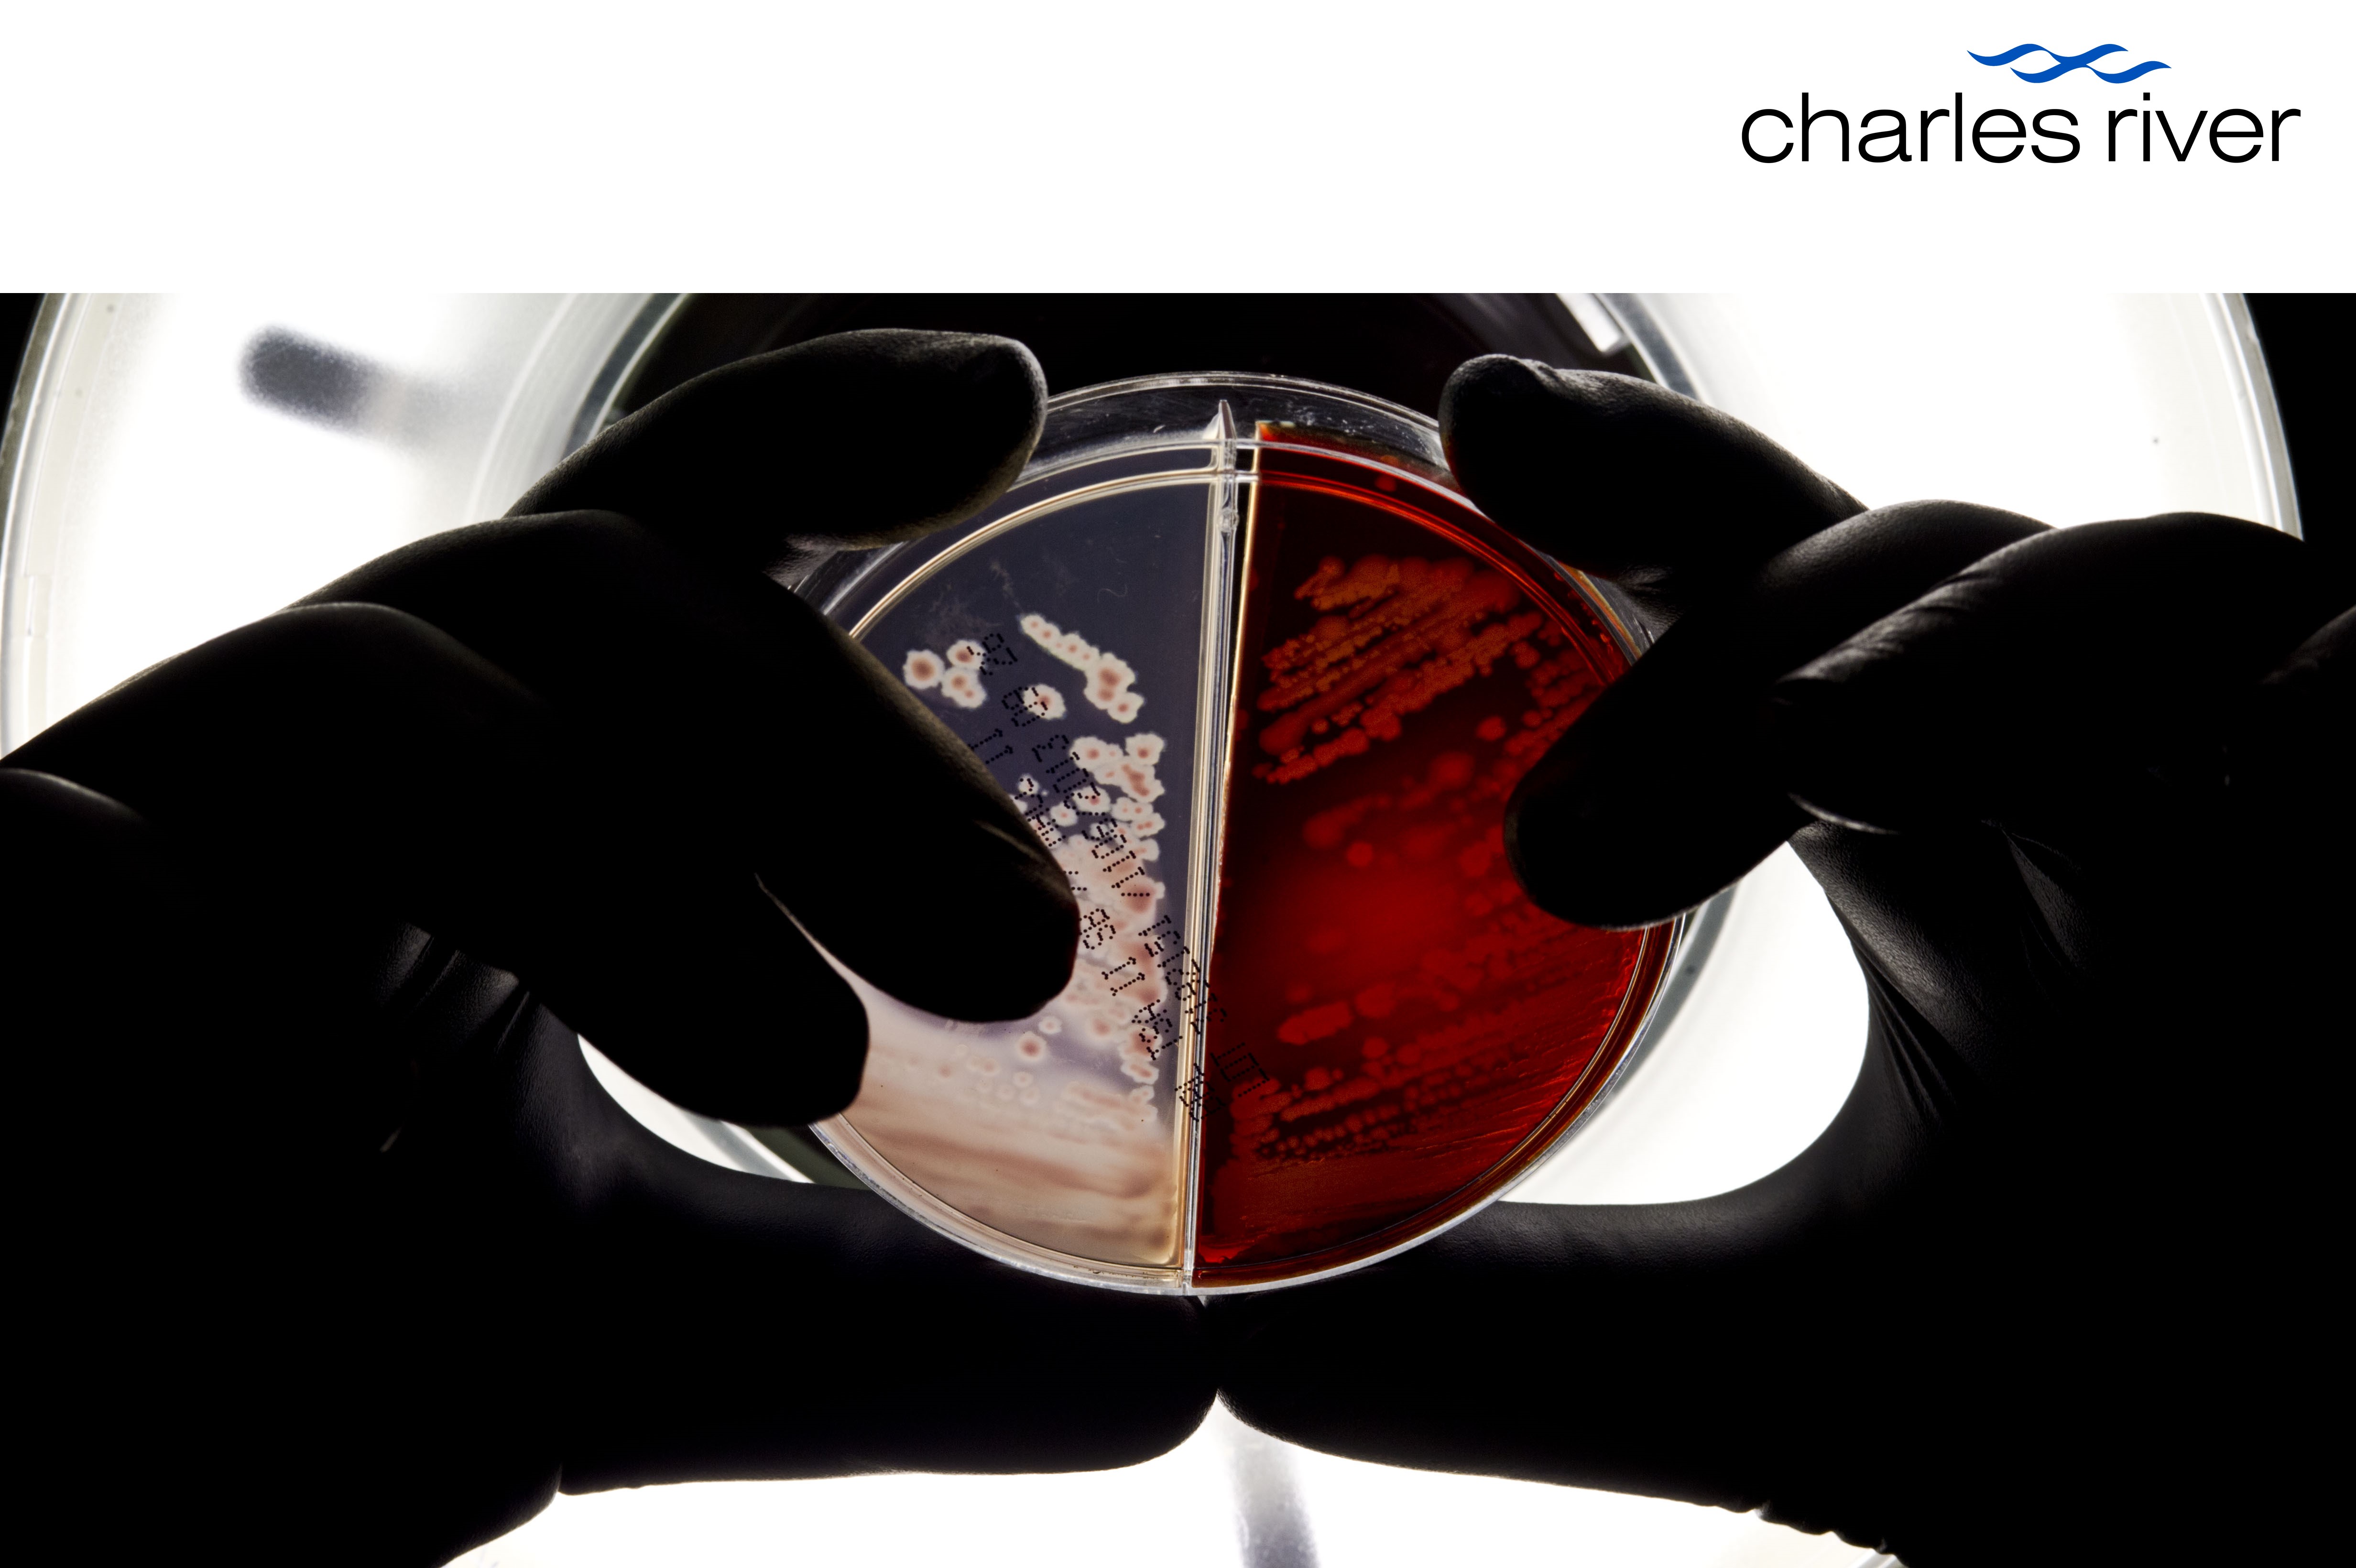

CHARLES RIVER BRASIL
Sobre
A Charles River fornece soluções abrangentes e inovadoras para testes de controle de qualidade microbiológico. Com um portfólio de produtos e serviços cuidadosamente desenvolvidos para entregar dados precisos, relevantes e confiáveis, a Charles River Microbial Solutions empodera as empresas a tomarem decisões mais assertivas sobre estratégias de controle de contaminação e eficiência dos processos industriais, garantindo que seus produtos atendam aos rigorosos padrões regulatórios globais.
Produtos
-
 EndosafeSolução completa para o Teste de Endotoxinas Bacterianas, desde reagentes, equipamentos e acessórios para métodos tradicionais até sistemas inovadores com tecnologia de testes rápidos e reagentes recombinantes que fornecem resultados precisos e confiáveis.
EndosafeSolução completa para o Teste de Endotoxinas Bacterianas, desde reagentes, equipamentos e acessórios para métodos tradicionais até sistemas inovadores com tecnologia de testes rápidos e reagentes recombinantes que fornecem resultados precisos e confiáveis. -
AccugenixServiços de identificação microbiana por análises de sequenciamento genético e MALDI-TOF que oferecem precisão incomparável na identificação de bactérias, leveduras e fungos filamentosos, utilizando bibliotecas de referência relevantes para ambientes industriais.
AccugenixServiços de identificação microbiana por análises de sequenciamento genético e MALDI-TOF que oferecem precisão incomparável na identificação de bactérias, leveduras e fungos filamentosos, utilizando bibliotecas de referência relevantes para ambientes industriais. -
 CelsisEquipamentos e reagentes de detecção microbiana rápida para acelerar liberação de produtos industriais, reduzir o ciclo de produção e aumentar a eficiência operacional.
CelsisEquipamentos e reagentes de detecção microbiana rápida para acelerar liberação de produtos industriais, reduzir o ciclo de produção e aumentar a eficiência operacional.



